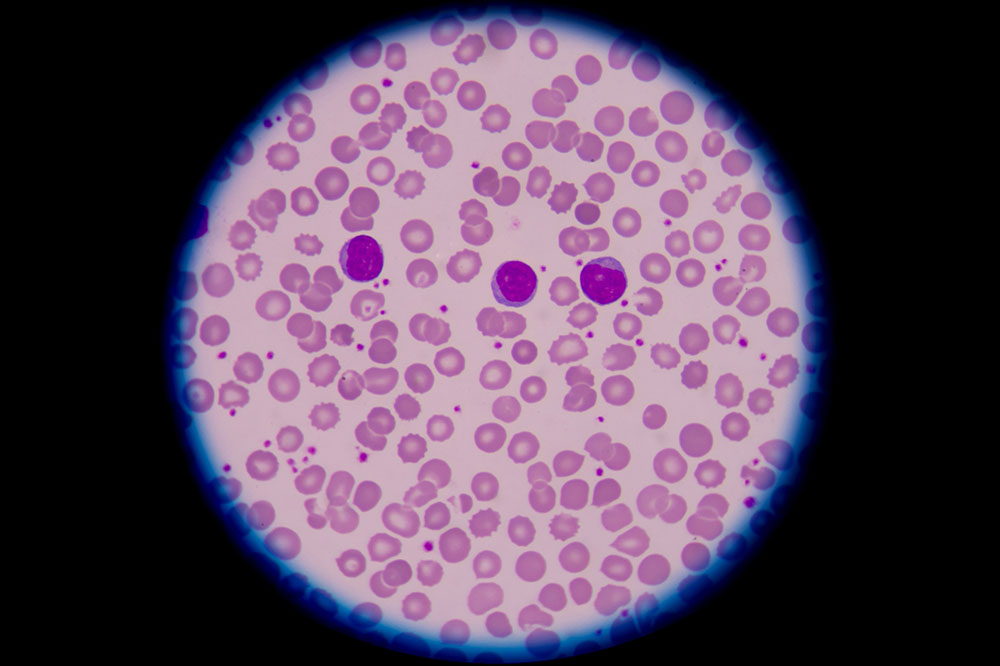
Types of blood disorders you must know about

Types of blood disorders you must know about
A blood disorder is a condition that impacts one or more parts of the blood and prevents it from functioning correctly. These parts are red blood cells, white blood cells, platelets. All these cell types form in the bone marrow, a soft tissue located inside one’s bones. There are various types of blood disorders, and their symptoms depend on the type. However, unexplained fatigue and weight loss are the two most common symptoms.

Red blood cell disorders
As the name indicates, this type of disorder affects one’s body’s red blood cells. These cells are responsible for carrying oxygen from one’s lungs to the rest of one’s body. There are several types of red blood cell disorders; these include:
- Anemia
Anemia is a prevalent blood disorder caused by the lack of mineral iron in the blood. The most common types of anemia include iron deficiency, pernicious, aplastic, autoimmune hemolytic, and sickle cell anemia.
- Thalassemia
It’s a group of inherited blood disorders caused by a genetic mutation, resulting in the interference of the natural hemoglobin production. Without enough hemoglobin, oxygen is not transferred to all areas of the body, which leads to complications.
- Polycythemia vera
It’s a blood cancer that occurs because of a gene mutation. The bone marrow of an individual suffering from polycythemia produces excess red blood cells, causing the blood to thicken and flow slowly. This may eventually lead to a heart attack or stroke.
White blood cell disorders
White blood cells guard one’s body against all infections. Any disorder in these cells can directly impact one’s body’s immune system and one’s ability to fight diseases. Some common white blood cell disorders include:
- Lymphoma
It’s a kind of blood cancer that affects an individual’s lymphatic system, causing the cells to change and multiply rapidly. Hodgkin’s lymphoma and non-Hodgkin’s lymphoma are the two main kinds of lymphoma.
- Leukemia
Leukemia is another type of blood cancer that leads to the multiplication of white blood cells in one’s bone marrow. They can either be acute and proliferate or chronic and grow gradually over time.
- Myelodysplastic syndrome (MDS)
MDS leads to the excess production of immature blood cells, called blasts, in the body. The syndrome can progress slowly or rapidly and sometimes lead to leukemia.
Platelet disorders
Blood platelets create a temporary plug to stop blood loss at the time of injury. An individual with blood platelet disorders can have very few platelets, or too many platelets, or deformed platelets which don’t clot properly. Some common conditions include:
- Von Willebrand disease
This disease is caused by the deficiency of the von Willebrand factor (VWF). It’s a substance that helps the blood clot.
- Hemophilia
Hemophilia is a well-known blood clotting disorder that is caused because of defective clotting. Since the blood doesn’t clot properly, it results in excessive and prolonged bleeding.
Plasma cell disorders
Plasma cells are the body’s white blood cells that are important for a body’s ability to battle diseases. A common plasma cell disorder is called plasma cell myeloma, a rare type of blood cancer that grows in the plasma cells in the bone marrow.